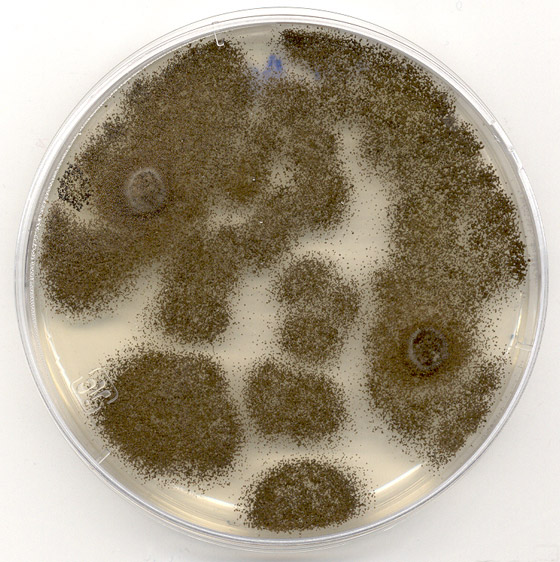
إليكم 5 حلول مبتكرة غير تقليدية للتخلص من أزمة النفايات البلاستيكية صورة رقم 1

إليكم 5 حلول مبتكرة غير تقليدية للتخلص من أزمة النفايات البلاستيكية
تعتبر أزمة البلاستيك واحدة من أكبر الأزمات البيئية التي يواجهها كوكبنا، خاصةً أن تحلُّل النفايات البلاستيكية يستغرق وقتاً طويلاً للغاية، وتعتبر من ملوثات المحيطات الأساسية، إذ ينتهي المطاف بـ12.7 مليون طن من البلاستيك إلى محيطاتنا كل عام، ومن جهة أخرى يستخدم سكان الأرض ما يقرب من تريليون كيس بلاستيك سنوياً وفقاً لتقارير أوردتها الأمم المتحدة.
وفي حين يعتبر الامتناع عن استخدام البلاستيك أو استعمال البلاستيك المكرر أحد الحلول التي يقترحها النشطاء البيئيون لتقليص أزمة النفايات البلاستيكية، يتوجه العلماء للتفكير في حلول مختلفة للتخلص من هذه الأزمة. إليكم 5 حلول غير تقليدية للتخلص من أزمة النفايات البلاستيكية:
1. نوع من الفطريات
في غالب الأحيان عندما تتكدس المكبات بالنفايات البلاستيكية ترمى هذه النفايات العنيدة والتي لا تتحلل بسهولة إلى قاع المحيطات، لتتسبب هناك في عرقلة حياة الكثير من المخلوقات المائية. لكن العلماء يقترحون استخدام فطر Aspergillus tubingensis لتحطيم البلاستيك في مكب النفايات، كيف ذلك؟ اكتشف العلماء أن هذه الفطريات الداكنة اللون تستطيع تحليل البولي يوريثين الموجود في البلاستيك.
فقد وجد جمع من علماء الأحياء في جامعة كويد عزام في باكستان، أن هذا النوع من الفطريات يُفرز إنزيمات تعمل على تحلل المواد البلاستيكية، وفي المقابل تحصل الفطريات على الطعام من خلال إذابة البلاستيك. وفي حال استطاع العلماء استثمار هذه الخاصية الموجودة في هذا النوع من الفطريات ستقدم لنا في هذه الحالة حلاً سحرياً لتقليص أزمة النفايات البلاستيكية.
2. طرق مصنوعة من البلاستيك

في الواقع هذه الفكرة دخلت بالفعل حيز التنفيذ في هولندا، فبدلاً من التخلص من الكميات الهائلة من النفايات البلاستيكية تتم إعادة تدويرها وتحويلها إلى مسارات لمرور الدراجات الهوائية. وضمن مشروع اتخذ اسم PlasticRoad أو "الطريق البلاستيكي" أصبح هناك مسار كامل للدراجات الهوائية على امتداد مدينة Zwolle الهولندية، حيث إن المسار مصنوع بالكامل من البلاستيك المعاد تدويره.
ويعتبر هذا المشروع الهولندي الأول من نوعه في العالم، ويقدم حلاً مبتكراً للاستفادة من النفايات البلاستيكية بدل التخلص منها في المحيطات. وقد بلغت نسبة البلاستيك المعاد تدويره في هذا المشروع 70%، لكن الخطط المستقبلية تقتضي استخدام البلاستيك المعاد تدويره بنسبة 100% في المشاريع المشابهة. وتقول الشركة المصنعة إن متانة الطريق أكبر من متانة الإسفلت، وإن تركيبه يستغرق وقتاً أطول ويتطلب معدات ثقيلة.
3. الأعشاب البحرية بدلاً من البلاستيك

دفعت الحرب ضد البلاستيك المهندسين والمصممين إلى البحث عن مواد أخرى يمكن استخدامها لتغليف المواد الغذائية، ووجدت شركة إندونيسية ناشئة الحل في الأعشاب البحرية. تعمل شركة Evoware الإندونيسية مع مزارعي الأعشاب البحرية المحليين لإنشاء أغلفة لشطائر البرغر وأكياس لتغليف القهوة والصابون، حيث إن جميع هذه الأغلفة مصنوعة من الأعشاب البحرية صديقة البيئة. يمكن إذابة الأغلفة المصنوعة من الأعشاب بسهولة في الماء الساخن، ولجعل نفايات هذه الأغلفة تساوي الصفر فإنها تكون صالحة للأكل كذلك.
4. بنك البلاستيك

أكبر مشكلة يُسببها البلاستيك هي تأثيره على الحياة في المحيطات. وبحلول عام 2050، وفقاً لبعض التقديرات، قد يكون عدد قطع البلاستيك أكثر من أعداد الأسماك في البحر. ولمنع البلاستيك من الوصول إلى البحار والمحيطات نشأت فكرة مؤسسة البلاستيك الاجتماعية أو "بنك البلاستيك". هذه المؤسسة تدفع سعراً أعلى من سعر السوق للنفايات البلاستيكية، بحيث يمكن للأشخاص الذين يجمعون البلاستيك استبداله مقابل الأموال أو مقابل خدمات اجتماعية معينة هم بحاجة إليها، مثل تسديد الرسوم المدرسية على سبيل المثال.
يحفز المشروع الناس على جمع النفايات البلاستيكية، ما يؤدي إلى تنظيف الشوارع وتقليل كميات النفايات التي ينتهي بها الأمر في المحيط، وكذلك تأمين دخل للعديد من الناس. الهدف من بنك البلاستيك هو جعل البلاستيك ثميناً للغاية، بحيث لا يمكن التخلص منه ورميه في المحيطات، ويقوم البنك ببيع البلاستيك المجموع لشركات تهتم بإعادة تدويره. هذه الفكرة هي قيد التطبيق حالياً بهايتي والبرازيل والفلبين، ومن المقرر العمل بها أيضاً في جنوب إفريقيا والهند وبنما والفاتيكان.
5. تنظيف المحيط من خلال System 001

أطلق مهندسون من هولندا، بقيادة مخترع هولندي يبلغ من العمر 24 عاماً يدعى بويان سلات، نظاماً لتنظيف المحيط أُطلق عليه اسم System 001. هذا النظام عبارة عن مجمع هائل للقمامة، يعوم على سطح المحيط بطول 600 متر وعمق 3 أمتار، ويقوم بالتقاط البلاستيك الملوث للمحيط. وتم إطلاق System 001 عام 2018، ليكون أول نظام تنظيف في العالم تتم تجربته في المحيط الهادئ.
أنت أيضاً تستطيع إحداث الفرق

بعيداً عن هذه الحلول المبتكرة التي تحتاج إلى دول ومؤسسات لدعمها، تستطيع أنت كفرد في المجتمع أن تسهم أيضاً في تقليل معاناة الكائنات البحرية والتقليل من حدة أزمة النفايات البلاستيكية. في حال كنت متحمساً للمشاركة ولا تعرف من أين تبدأ، إليك بعض الأفكار:
1. التخلي عن الأكياس البلاستيكية: اصطحِب أكياساً يمكن إعادة استخدامها إلى المتجر للاستعاضة عن الأكياس البلاستيكية.
2. لا تستخدم الماصّة (الشلموه) ما لم تكن لديك احتياجات طبية، وحتى مع ذلك يمكنك استخدام ماصات من الورق.
3. لا تشتري المشروبات المعبأة في الزجاجات البلاستيكية، لا تنسَ أنه يتم بيع ما يقرب من مليون زجاجة مشروبات بلاستيكية كل دقيقة على المستوى العالمي، تستطيع أن تتخيل حجم النفايات الناتجة عنها.
4. تجنب العبوات البلاستيكية، وإذا كان لا بد لك من ذلك اشترِ منجاتك في العبوات كبيرة الحجم بدلاً من شراء عدة علب صغيرة، وقم بالاستغناء عن الأطباق والأكواب البلاستيكية.
5. إعادة تدوير البلاستيك إن أمكن: حتى في الدول الغنية، تعتبر معدلات إعادة التدوير منخفضة. على الصعيد العالمي يتم إعادة تدوير 18% من إجمالي البلاستيك فقط، إذا كنت تعيش في دولة يتاح فيها خيار إعادة التدوير، اجمع قمامتك البلاستيكية ولا تتردد في إعادة تدويرها.











 للتواصل معنا
للتواصل معنا 